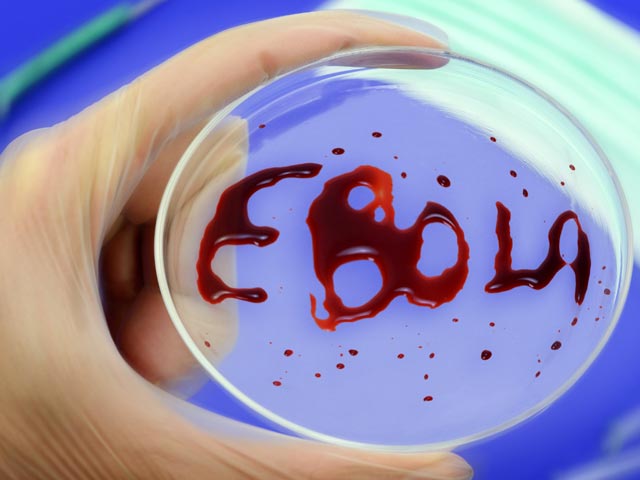

В Россию вернется тысяча курсантов из Африки. Их берут на контроль из-за вируса Эбола
В Россию вскоре вернется тысяча военнослужащих из Африки. Их возьмут на контроль в связи со вспышкой лихорадки Эбола, которая охватывает все больше стран.
Российские военнослужащие в Африке постоянно наблюдаются специалистами на предмет предотвращения болезни, вызванной вирусом Эбола, сообщил в эфире "Русской службы новостей" заместитель начальника Главного медицинского управления Минобороны РФ Константин Кувшинов.
"Наш контингент есть в Африке. Мы получаем по каждому всю информацию. В настоящее время с российскими военнослужащими работают наши специалисты. Самое главное - наблюдение, каких-то профилактических мер не существует, - цитирует "Интерфакс". - К началу учебного года ожидается возвращение оттуда около 1000 курсантов. Военные медики будут наблюдать за их состоянием здоровья".
По словам Кувшинова, в случае необходимости для пациентов будут организованы специальные боксы, которые позволят осуществить забор крови и другие медицинские процедуры.
Вспышки лихорадки Эбола были зафиксированы в Либерии (почти 700 погибших), Сьерра-Леоне, Гвинее (в обеих странах более 400), Нигерии и Конго (менее 10). В нигерийском городе Порт-Харкот от вируса скончался врач, лечивший инфицированного американца Патрика Сойера. О состоянии последнего информации нет. Количество людей, зараженных лихорадкой Эбола, от которой, как считается, не существует никаких вакцин, кроме экспериментальной, может превысить 20 тысяч человек.
Накануне первый случай заражения зафиксирован в Сенегале.
Отметим, что с экспериментальным лекарством от лихорадки пока все сложно: двое пациентов, которые лечились созданным в США препаратом ZMapp, излечились. Между тем другому пациенту лекарство не помогло. По информации Reuters, ученые тем временем утверждают, что в ходе проведенных на обезьянах опытов от лихорадки Эбола излечились все 18 приматов, зараженных этим вирусом.